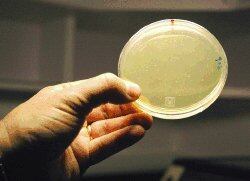

Un grupo de investigadores costarricenses pretende utilizar una proteína -que hace que una medusa brille en la oscuridad- como marcador para saber si una vaca está vacunada contra la brucelosis.
Esta ingeniosa idea logrará acabar con un problema que viven los ganaderos. Desde hace 75 años existe una vacuna eficaz (la S19) contra esa enfermedad, que produce abortos espontáneos en las vacas.
Sin embargo, dicha vacuna tiene un inconveniente: produce los mismos anticuerpos en el animal que la infección por la bacteria.
Eso hace que, cuando se sospecha que hay un brote de la brucelosis animal, sea imposible separar las vacas vacunadas de las enfermas y, por ende, se deba sacrificar a todas.
El sacrificio se hace para evitar que más vacas enfermen, pero también para impedir una transmisión de la bacteria a los seres humanos.
La brucelosis humana es una de las cinco enfermedades bacterianas más importantes del planeta.
Cada año, unas 500.000 personas en el mundo padecen de brucelosis y deben someterse a un tratamiento de ocho semanas de antibióticos para curarse.
Con la vacuna fluorescente se pretende eliminar ese problema.
Al agregar la proteína fluorescente verde (GTP por sus siglas en inglés), será posible detectar a una vaca vacunada con solo observar su leche bajo luz ultravioleta.
Los gestores de esta idea son expertos en las bacterias del género Brucella .
Ellos son Caterina Guzmán-Verri, Edgardo Moreno y Melissa Muñoz -de la Universidad Nacional (UNA)- y Esteban Chaves Olarte, de la Universidad de Costa Rica.
El proyecto se desarrolló en el Programa de Investigación en Enfermedades Tropicales (PIET), de la UNA, y acaba de recibir un empujón económico de $25.000.
La investigación es una de las cuatro ganadoras del premio Aportes a la Creatividad y la Excelencia de la empresa Florida Ice & Farm, Co.
Bacterias fluorescentes
En el laboratorio, esos científicos ya han dado uno de los principales pasos para obtener la vacuna fluorescente: han incorporado la proteína GTP a la bacteria que se utiliza en la vacuna.
Con el uso de pequeños shocks eléctricos, han logrado que la membrana que recubre la célula bacteriana se abra y por ahí ingrese el plásmido que lleva la GTP.
"El uso de marcadores fluorescentes es una tecnología que nunca antes había sido utilizada en el país", indicó Edgardo Moreno, director del PIET.
El siguiente paso del estudio consiste en probar que la vacuna fluorescente es igual de eficaz y segura que la normal.
Para ello harán pruebas en cultivos celulares en el laboratorio, luego en ratones y por último en ganado.
Si resulta efectiva, la vacuna marcada con la proteína fluorescente podría ser utilizada en las ganaderías de todo el mundo.